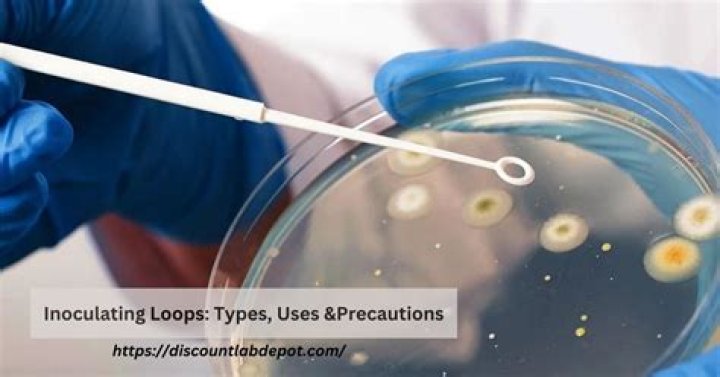

Why sterilize inoculating loop?
The inoculating loop is sterilised by passing it at an angle through the flame of a gas burner until the entire length of the wire becomes orange from the heat. In this way all contaminants on the wire are incinerated. Never lay the loop down once it is sterilised, or it may again become contaminated.
Why is it important to sterilize your inoculating loop before and after each use?
The loop is sterilized after the initial inoculum is put on to avoid contamination of other microbes or impurities. A pure culture is composed of one form of bacteria or microbes solely, whereas a mixed culture is composed of a mixture of microbes (Morello, J.
Why is it important to sterilize the inoculating loop?
Flame-sterilize the inoculating loop in order to prevent contamination of the bench surface and as a consideration to others in the lab who may later use the inoculating loops.
What is a sterile inoculating loop?
Sterile, disposable inoculating loops do not require flaming. Loops are made from a plastic resin that provides controlled flexibility. They resist cutting the agar surface yet provide sufficient firmness to pick stubborn colonies. Loops are color-coded for quick ID.
Why do you flame sterilize the loop again after transferring the bacteria to the slide?
Why should you flame the mouth of a tube? Flaming the mouth of the tube prevents airborne bacteria from entering the tube while it is uncapped. Airborne bacteria may fall anywhere on this slant and grow to form a colony.
Sterilizing a loop
28 related questions foundWhy is sterile technique important give two reasons?
a technique for isolating pure cultures by spreading organisms on an agar plate. Why is sterile technique important? This technique is important because it prevents contamination of your culture with organisms from the environment and to prevent the culture from contaminating you or others.
When should your inoculating loop be sterilized in the Bunsen burner or incinerator?
Inoculating Loops for MALDI-TOF
That's because inoculation loops must be thoroughly sterilized (autoclaved) using a micro incinerator or bunsen burner for at least 5-10 seconds between every streak or sample. Working this way also means introducing an open flame into your otherwise still air environment.
Why is it important to maintain asepsis?
Why Aseptic Technique Is Important
The simplest and safest way to prevent infection is to keep things as clean as possible. Aseptic technique does just that. It's designed to keep dangerous bacteria and other microorganisms out of wounds and protect you from infections when you're recovering.
How can inoculating needle be sterilized?
The inoculation needle is sterilized using the aseptic technique. An open flame from an incinerator, a bunsen burner, or an alcohol burner is used to flame along the tip and the length of the needle that is to be in contact with the inoculum (or the propagule).
What is the purpose of transfer of bacteria aseptic technique?
Finally, in working with microorganisms, we must have a method of transferring growing organisms (called the inoculum) from a pure culture to a sterile medium without introducing any unwanted outside contaminants. This method of preventing unwanted microorganisms from gaining access is termed aseptic technique.
What is the purpose of heat fixing the smear?
Heat fixation ensures the elimination of contaminating organisms from the smear preparation. Heat fixation adheres the cells to the slide and coagulates the bacterial proteins, effectively killing the bacteria.
What is the process of sterilization?
Sterilization describes a process that destroys or eliminates all forms of microbial life and is carried out in health-care facilities by physical or chemical methods. ... Disinfection describes a process that eliminates many or all pathogenic microorganisms, except bacterial spores, on inanimate objects (Tables 1 and 2).
Why is boiling an ineffective means of sterilizing microbial media?
6. Why is boiling an ineffective means of sterilizing microbal media? ... Endospores can withstand boiling temperatures.
What is the most important part of using a metal loop in transferring bacteria?
An inoculation loop is a thin metal device with a handle at one end and a looped wire at the other end. The looped end is useful for obtaining bacterial samples from colonies growing on media plates or from liquid media, as the loop can hold a drop of liquid, somewhat like a bubble wand holds liquid soap.
Why is a sterile field important?
Maintaining a sterile field is an important component of infection prevention. These set of practices that are performed before, during and after invasive procedures reduce the number of potentially infectious microbes and help to reduce the risk of post procedure infection.
Why is working under sterile conditions important?
Sterile technique is ESSENTIAL when working with microorganisms! It is important to protect strains from contamination with other strains and from the many undefined microbes in the environment. ... Correct transfer techniques and the use of sterile reagents are usually enough to prevent contamination.
What is the difference between sterile and aseptic?
Aseptic: A surface, object, product, or environment has been treated such that it is free of contamination. Bacteria, viruses, or other harmful living organisms cannot survive or reproduce. ... Sterile: A product that is completely free of microscopic organisms.
Why is the loop sterilized after the initial inoculum?
The loop is sterilized after the initial inoculum is put on to avoid contamination of other microbes or impurities. A pure culture is composed of one form of bacteria or microbes solely, whereas a mixed culture is composed of a mixture of microbes (Morello, J.
Why is it important to use sterile technique during the streak plate method?
Always use sterile equipment to spread the inoculum. Flame the loop or use a new disposable loop after you streak each quadrant. Using a new or sterilized loop allows you to effectively dilute the inoculum on the plate and obtain isolated colonies by spreading the inoculum thinner and more evenly.
Why is dilution a necessary part of culture preparation?
Why is dilution a necessary part of pure culture preparation? When working with culture that may contain millions of cells, dilution on to a solid medium is essential for separating the cell with enough space so that they grow into isolated colonies.
Why should you never use your loop immediately after sterilizing it in the incinerator?
Because flaming in this direction limits aerosol production by allowing the tip to heat up more slowly than if it were put into the flame immediately. When making a transfer, which should you move; the culture tube in your nondominant hand or the loop in your dominate hand?
What are the reasons for fixing bacterial smears?
The purpose of making a smear is to fix the bacteria onto the slide and to prevent the sample from being lost during a staining procedure.
Why do we need to heat fix your bacterial slides after smearing them?
Smears are ready to heat fix when they are completely air-dried. ... The purpose of heat-fixing a smear is to make the cells stick to the slide.
What would happen if no heat fixing were done?
The real problem is this: Heat fixing will stick the bacteria to the slide. ... Thus, if you do not heat fix, it is extremely likely that you will wash off your bacteria, leaving little to none to be seen under the microscope.



